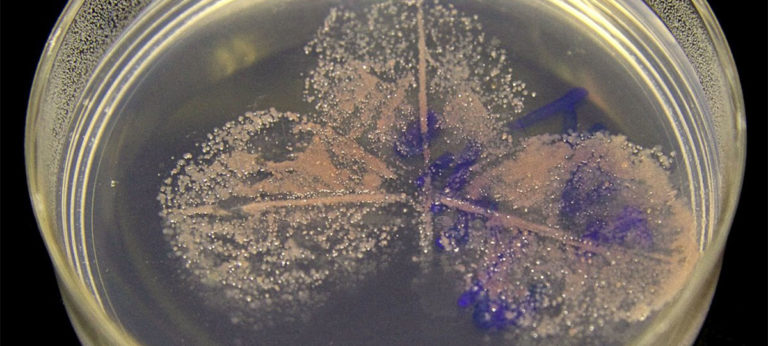

KnipBio, la empresa de biotecnología con sede en Massachusetts, es el primer fabricante de proteínas unicelulares que presta servicios a la industria de alimentos acuícolas en obtener la designación de Considerado como Seguro por la Administración de Medicamentos y Alimentos de EE.UU. (GRAS)